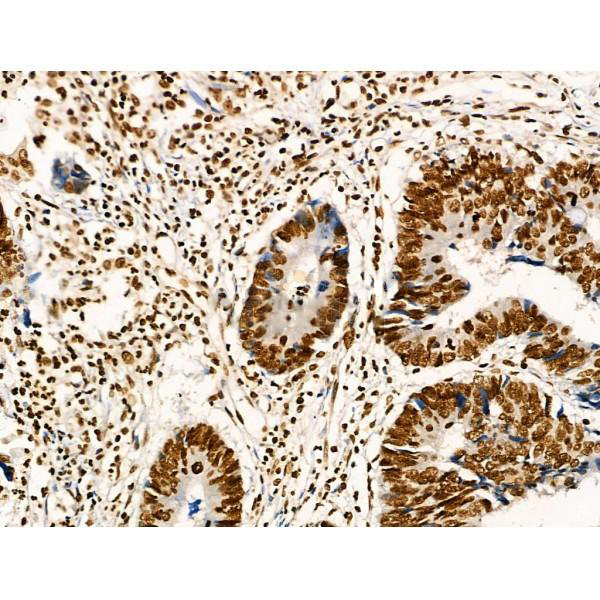
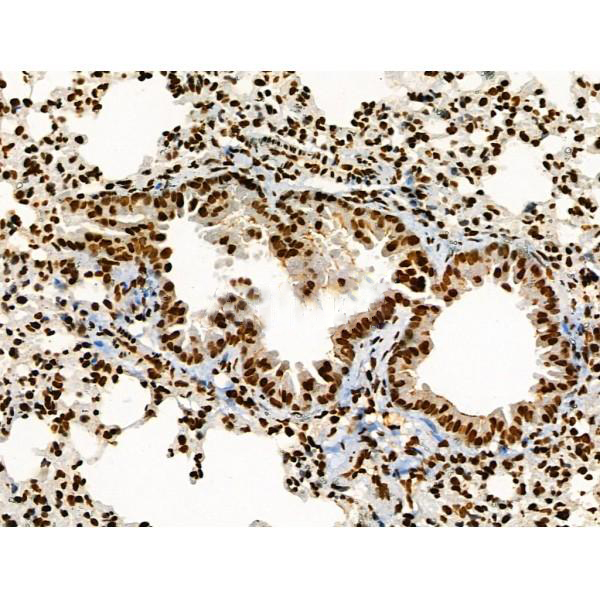

Acts as a tumor suppressor in many tumor types; induces growth arrest or apoptosis depending on the physiological circumstances and cell type. Involved in cell cycle regulation as a trans-activator that acts to negatively regulate cell pision by controlling a set of genes required for this process. One of the activated genes is an inhibitor of cyclin-dependent kinases. Apoptosis induction seems to be mediated either by stimulation of BAX and FAS antigen expression, or by repression of Bcl-2 expression. Its pro-apoptotic activity is activated via its interaction with PPP1R13B/ASPP1 or TP53BP2/ASPP2. However, this activity is inhibited when the interaction with PPP1R13B/ASPP1 or TP53BP2/ASPP2 is displaced by PPP1R13L/iASPP. In cooperation with mitochondrial PPIF is involved in activating oxidative stress-induced necrosis; the function is largely independent of transcription. Induces the transcription of long intergenic non-coding RNA p21 (lincRNA-p21) and lincRNA-Mkln1. LincRNA-p21 participates in TP53-dependent transcriptional repression leading to apoptosis and seems to have an effect on cell-cycle regulation. Implicated in Notch signaling cross-over. Prevents CDK7 kinase activity when associated to CAK complex in response to DNA damage, thus stopping cell cycle progression. Isoform 2 enhances the transactivation activity of isoform 1 from some but not all TP53-inducible promoters. Isoform 4 suppresses transactivation activity and impairs growth suppression mediated by isoform 1. Isoform 7 inhibits isoform 1-mediated apoptosis. Regulates the circadian clock by repressing CLOCK-ARNTL/BMAL1-mediated transcriptional activation of PER2.
Description
Rabbit polyclonal antibody to Acetyl-p53 (Lys373)
Applications
WB, IHC.
Immunogen
Acetyl-p53 (Lys373) Antibody detects endogenous levels of Acetyl-p53 only when acetylated at Lys373.
Reactivity
Human, Mouse, Rat.
可预测:Pig(91%), Sheep(80%), Rabbit(91%), Dog(91%)
Molecular weight
43.7kDa; 44kD(Calculated).
Host species
Rabbit
Ig class
Immunogen-specific rabbit IgG
Purification
Antigen affinity purification
Full name
Acetyl-p53 (Lys373)
Synonyms
Antigen NY-CO-13; BCC7; Cellular tumor antigen p53; FLJ92943; LFS1; Mutant tumor protein 53; p53; p53 tumor suppressor; P53_HUMAN; Phosphoprotein p53; Tp53; Transformation related protein 53; TRP53; Tumor protein 53; Tumor protein p53; Tumor suppressor p53;
Storage
Rabbit IgG in phosphate buffered saline , pH 7.4, 150mM NaCl, 0.02% sodium azide and 50% glycerol. Store at -20 °C. Stable for 12 months from date of receipt.
Swissprot
P04637




 产品订购:
产品订购:
 渠道电话:
渠道电话: